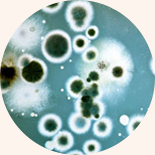

乙肝病毒的表面抗原(HBsAg) 作用于人体免疫细胞,保护病毒,不让机体免疫系统清除病毒。

乙肝病毒扎根于肝细胞核内,常规药物分子过大无法直达肝细胞核心病灶部位。

乙肝病毒擅长“伪装”自己易变异,逃脱免疫识别,不让机体免疫系统清除病毒。



专业8大项特色检测,精准检测病毒毒性基因,病毒类型以及c区病毒基因整合变异耐药情况。


通过静脉点滴方式局部直接给药,迅速直达病灶部位。


源头切入,解决肝细胞核心病毒问题真正改变肝细胞理化环境,使病毒蛋白部件形成畸形,实现临床康复。

结合“生物疫苗系列针剂”源头解决肝细胞核心内病毒母版及外周血液病毒,全面彻底绿色无副作用。















* 本网站已加密,绝对保障个人隐私